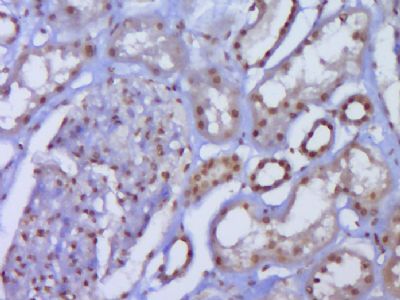
产品细节图片6

相关产品推荐更多 >
万千商家帮你免费找货
0 人在求购买到急需产品
- 详细信息
- 文献和实验
- 技术资料
- 供应商:
上海康朗生物科技有限公司
- 库存:
大量
- 目录编号:
kl-2592R
- 克隆性:
多克隆
- 抗原来源:
Rabbit
- 保质期:
12个月
- 抗体英文名:
JNK1+JNK2+JNK3 antibody
- 抗体名:
氨基末端激酶1/2/3抗体
- 宿主:
Rabbit
- 适应物种:
Human, Mouse, Rat, Dog, Pig, Cow,
- 免疫原:
KLH conjugated synthetic peptide derived from human JNK1/2/3:151-250/384
- 亚型:
IgG
- 形态:
冻干粉或液体
- 应用范围:
WB=1:500-2000 ELISA=1:500-1000 IHC-P=1:400-800 IHC-F=1:400-800 Flow-Cyt=1ug/Test IF=1:100-500
- 浓度:
1mg/ml
- 保存条件:
-20 °C
- 规格:
50ul 100ul 200ul
| 中文名称 | 氨基末端激酶1/2/3抗体 |
| 别 名 | JNK1 + JNK2 + JNK3; JNK1/2/3; JNK1+2+3; JNK1 + JNK2 + JNK3; MAPK10; c Jun N terminal kinase 1; c Jun N terminal kinase 2; c Jun N terminal kinase 3; JNK; JNK1; JNK2; JNK2ALPHA; JNK2BETA; JNK3; MAPK8; MAPK9; Mitogen activated protein kinase 10; Mitogen activated protein kinase 8; Mitogen activated protein kinase 9; SAPK(beta); Stress activated protein kinase JNK1; Stress activated protein kinase JNK2; Stress activated protein kinase JNK3; SAPK; p54a; JNK2A; JNK2B; PRKM9; JNK-55; SAPK1a; JNK2BETA; p54aSAPK; JNK2ALPHA. |
![]() |
Specific References (1) | bs-2592R has been referenced in 1 publications. [IF=2.42] Li, Mingyong, et al. "c-Jun N-Terminal Kinase is Upregulated in Patients With Hypospadias." Urology 81.1 (2013): 178-183. IHC-P ; Human. PubMed:23273084 |
| 规格价格 | 50ul/780元 购买 100ul/1380元 购买 200ul/2200元 购买 大包装/询价 |
| 说 明 书 | 50ul 100ul 200ul |
| 研究领域 | 细胞生物 细胞凋亡 糖尿病 |
| 抗体来源 | Rabbit |
| 克隆类型 | Polyclonal |
| 交叉反应 | Human, Mouse, Rat, Dog, Pig, Cow, |
| 产品应用 | WB=1:500-2000 ELISA=1:500-1000 IHC-P=1:400-800 IHC-F=1:400-800 Flow-Cyt=1ug/Test IF=1:100-500 (石蜡切片需做抗原修复) not yet tested in other applications. optimal dilutions/concentrations should be determined by the end user. |
| 分 子 量 | 42-47kDa |
| 细胞定位 | 细胞核 细胞浆 |
| 性 状 | Lyophilized or Liquid |
| 浓 度 | 1mg/ml |
| 免 疫 原 | KLH conjugated synthetic peptide derived from human JNK1/2/3:151-250/384 |
| 亚 型 | IgG |
| 纯化方法 | affinity purified by Protein A |
| 储 存 液 | 0.01M TBS(pH7.4) with 1% BSA, 0.03% Proclin300 and 50% Glycerol. |
| 保存条件 | Store at -20 °C for one year. Avoid repeated freeze/thaw cycles. The lyophilized antibody is stable at room temperature for at least one month and for greater than a year when kept at -20°C. When reconstituted in sterile pH 7.4 0.01M PBS or diluent of antibody the antibody is stable for at least two weeks at 2-4 °C. |
| PubMed | PubMed |
| 产品介绍 | background: JNK1(MAPK8) is a member of the MAP kinase family. JNK1 is activated by threonine and tyrosine phosphorylation by either of two dual specificity kinases, MAP2K4 and MAP2K7. JNK2 (p54a, SAPK1a), along with JNK1 and JNK3, is thought to play an important role in nuclear signal transduction through its environmental stress activation and subsequent phosphorylation of the nuclear transcription factor p53. JNK3 is a neuron-specific form of c-Jun N-terminal kinases. Through its phosphorylation and nuclear localization, this kinase plays regulatory roles in the signaling pathways of neuronal apoptosis. The JNK pathway is critically involved in diabetes and levels are abnormally elevated in obesity. SWISS: Q61831 Gene ID: 5599 Database links: Entrez Gene: 5599 Human Entrez Gene: 26419 Mouse Entrez Gene: 116554 Rat Omim: 601158 Human JNK1 SwissProt: P45983 Human JNK1 Unigene: 138211 Human JNK1 Unigene: 21495 Mouse JNK1 Unigene: 4090 Rat JNK1 Entrez Gene: 5601 Human JNK2 Important Note: This product as supplied is intended for research use only, not for use in human, therapeutic or diagnostic applications. |
| 产品图片 | ![]() Sample: Kidney (Mouse) Lysate at 40 ug Primary: Anti-JNK1+JNK2+JNK3 (bs-2592R) at 1/300 dilution Secondary: IRDye800CW Goat Anti-Rabbit IgG at 1/20000 dilution Predicted band size: 42-47 kD Observed band size:42-52 kD ![]() Sample: Hela(Human) CellLysate at 30 ug Primary: Anti-JNK1+JNK2+JNK3 (bs-2592R) at 1/300 dilution Secondary: IRDye800CW Goat Anti-Rabbit IgG at 1/20000 dilution Predicted band size: 42-47 kD Observed band size:42-52 kD ![]() Sample: K562 (Human) Lysate at 30 ug Primary: Anti-JNK1+JNK2+JNK3 (bs-2592R) at 1/300 dilution Secondary: IRDye800CW Goat Anti-Rabbit IgG at 1/20000 dilution Predicted band size: 42-47 kD Observed band size:42-52 kD ![]() Paraformaldehyde-fixed, paraffin embedded (mouse brain tissue); Antigen retrieval by boiling in sodium citrate buffer (pH6.0) for 15min; Block endogenous peroxidase by 3% hydrogen peroxide for 20 minutes; Blocking buffer (normal goat serum) at 37°C for 30min; Antibody incubation with (JNK1+JNK2+JNK3) Polyclonal Antibody, Unconjugated (bs-2592R) at 1:400 overnight at 4°C, followed by a conjugated secondary (sp-0023) for 20 minutes and DAB staining. ![]() Paraformaldehyde-fixed, paraffin embedded (Human kidney); Antigen retrieval by boiling in sodium citrate buffer (pH6.0) for 15min; Block endogenous peroxidase by 3% hydrogen peroxide for 20 minutes; Blocking buffer (normal goat serum) at 37°C for 30min; Antibody incubation with (JNK1+JNK2+JNK3) Polyclonal Antibody, Unconjugated (bs-2592R) at 1:400 overnight at 4°C, followed by operating according to SP Kit(Rabbit) (sp-0023) instructionsand DAB staining. ![]() Tissue/cell: rat brain tissue; 4% Paraformaldehyde-fixed and paraffin-embedded; Antigen retrieval: citrate buffer ( 0.01M, pH 6.0 ), Boiling bathing for 15min; Block endogenous peroxidase by 3% Hydrogen peroxide for 30min; Blocking buffer (normal goat serum,C-0005) at 37℃ for 20 min; Incubation: Anti-JNK1/2/3 Polyclonal Antibody, Unconjugated(bs-2592R) 1:200, overnight at 4°C, followed by conjugation to the secondary antibody(SP-0023) and DAB(C-0010) staining ![]() Blank control (Black line): HUVEC (Black). Primary Antibody (green line): Rabbit Anti-JNK1+JNK2+JNK3 antibody (bs-9587R) Dilution: 3μg /10^6 cells; Isotype Control Antibody (orange line): Rabbit IgG . Secondary Antibody (white blue line): Goat anti-rabbit IgG-AF647 Dilution: 1μg /test. Protocol The cells were fixed with 4% PFA (10min at room temperature)and then permeabilized with 90% ice-cold methanol for 20 min at room temperature. The cells were then incubated in 5%BSA to block non-specific protein-protein interactions for 30 min at room temperature .Cells stained with Primary Antibody for 30 min at room temperature. The secondary antibody used for 40 min at room temperature. Acquisition of 20,000 events was performed. |
风险提示:丁香通仅作为第三方平台,为商家信息发布提供平台空间。用户咨询产品时请注意保护个人信息及财产安全,合理判断,谨慎选购商品,商家和用户对交易行为负责。对于医疗器械类产品,请先查证核实企业经营资质和医疗器械产品注册证情况。
文献和实验Generation of Antibody Molecules Through Antibody Engineering
been overcome to a large extent using genetic-engineering techniques to produce chimeric mouse/human and completely human antibodies. Such an approach is particularly suitable because of the domain structure of the antibody molecule ( 2 ), where functional
The importance of antibody molecules was first recognized in the 1890s, when it was shown that immunity to tetanus and diphtheria was caused by antibodies against the bacterial exotoxins (1 ). Around the same time, it was shown that antisera
General comments: Antibodies, like most proteins, do not like to be freeze-thawed. Avoid repetitive freezing of your solution. The best way to store your antibody is to keep a high protein concentration (>1 mg/ml), add some protease
技术资料暂无技术资料 索取技术资料